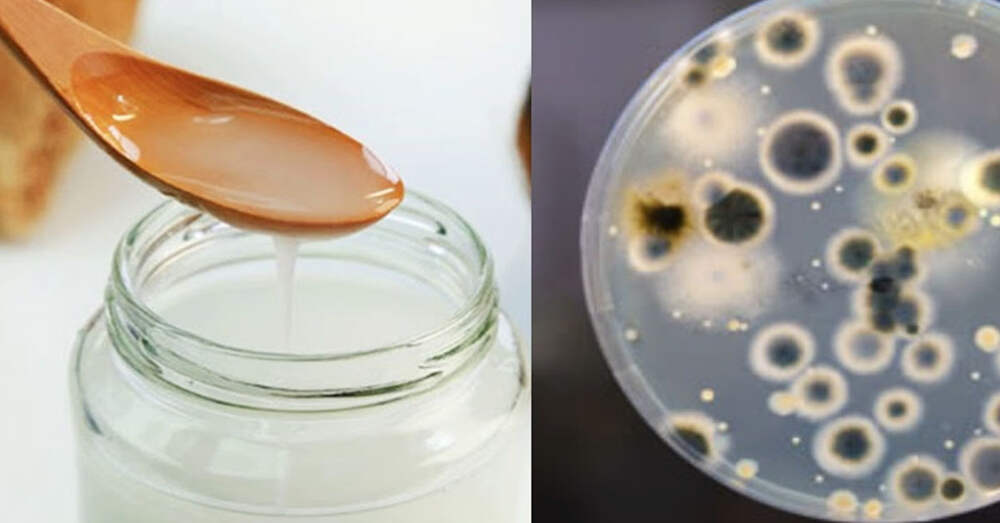

Вот как сделать здоровый тахини быстрым способом для чистых сосудов и сильного сердца
Идеальный источник питательных веществ для организма в пасте с ореховым вкусом, которую можно добавлять в различные блюда! Тахини или тахина — это паста, изготовленная из семян кунжута, она используется во многих ближневосточных рецептах, таких как хумус или баба гануш. Мы собираемся немного
...Далее

Свежие комментарии